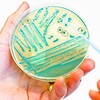

Fritekstsøgning
Indholdstyper
-

Kan en cobot gribe enhver genstand ved automatiseret palletering?
I en automatiseret palleteringsproces er valget af den rette robotgriber afgørende for at optimere din palleteringsløsning. Uanset om du skal håndtere store for...
-

Otte ventilatorer til spraytørringsanlæg
Hos BarkerBille har vi designet og leveret disse tre rustfrie ventilatorer og fem mindre fra vores fabrik i Holsted.
-

Fuld dokumenteret FKM-godkendt polycarbonat tilgængeligt hos Induflex
Polycarbonat (PC) har længe været et populært materiale i industrien, men nu kan det også bruges til fødevareapplikationer takket være fuld fødevarekontaktgodke...
-

SICK og Endress+Hauser etablerer et joint venture
De to globale aktører inden for procesautomation indgår et strategisk partnerskab
-
Producentansvaret for emballage omfatter ikke kun producenter
Er du også forvirret i forhold til lovgivningen om producentansvaret for emballage? Selvom navnet antyder det, er det nemlig ikke kun producenter, der er omfattet.
-

Vi søger en Teknisk Account Manager
AVS Danmark søger en Account Manager, der trives med at danne relationer og som vil sælge innovative, tekniske løsninger indenfor luftfiltrering til industrien.
-

Nu vælges Danmarks repræsentant til ’EM i elektrikerfaget’
EuroSkills kommer til Danmark i 2025. Det bliver dermed på hjemmebane, at landets skarpeste unge elektrikere skal kæmpe mod resten af Europas talenter. Hvem, de...
-

Direkte Gasfyret Ovn og Hybridovn
DGF-konceptet (Direct Gas Fired) er designet til at gøre det lettere at bage ved højere temperaturer med øget fugtighed i de indledende faser af bageprocessen. ...
-

Kompressor kampagne hos Granzow
Efteråret er så småt over os, og hos Granzow har vi derfor skarpe efterårstilbud på Jun-Air kompressorer hos Granzow. Som en del af vores efterårskampagne tilby...
-
Frokostwebinar om mikrofloraundersøgelser i fødevarer
Lær, hvordan vi bruger DNA-sekventering til at undersøge fødevarer og produktionsmiljøer for bakterier og anden mikroflora.
-

Hvor meget betaler du egentlig for din Tachodata køre hviletids opbevaring og rapportering?
Tjek TachoMan Cloud tilbuddet: kvalitet og pris uden konkurrence, da vi prismatcher og mere til. Nu har du mulighed for at komme med ombord på en uafhængig løsn...
-

Newtronic opkøber TRANEX A/S
Det er med stor glæde, at vi byder TRANEX A/S velkommen i Newtronic-familien.
-

Konecranes Webserie - Smart Features del 3 af 3
I denne spændende serie deler vores eksperter Allan Kronborg (Sales Engineer) og Søren Brandborg (Sales Manager) ud af sin brede viden om Smart Features.
-

Sikkerheds-lynkoblinger
Brd. Klee forhandler sikkerheds-lynkoblinger i høj kvalitet, robust- og holdbarhed.
-

Calpeda centrifugalpumpe i støbejern til mange typer anvendelse
Til forsyning af vand og vandingssystemer, til civile og industrielle applikationer, til brandbekæmpelse, opvarmning, aircondition, køling og cirkulationssystemer.
-

TILBUD - GYSFLASH 6.12 Lithium batterilader - ideel til biler og motorcykler
Designet til 12 V batterier fra 1,2 til 125 Ah eller til vedligeholdelsesopladning op til 170 Ah. TILBUD DKK 430,-
-

Nyt løfteåg med ultra lav egenvægt? - Fyns Kran Udstyr A/S
Så skal du se på vores løfteåg i aluminium!
-

EtherCAT til bygningsautomation
Energieffektiv og bæredygtig bygningsdrift - lige fra energistyring, tilvejebringelse af opladningsinfrastruktur til elektromobilitet og registrering af energi-...
-

Memorycards til S7 serie 1200/1500 fra Helmholz til yderst favorable priser
Helmholz har i mange år produceret færdig konfigurerede Memory Cards til S7-1200 /1500 serien, der er lige klar til brug. Priserne er yderst favorable og de fle...
-

Har du set vores tryklufttilbud på alle Jun-air kompressorer?
Hos Granzow A/S har vi kun trykluft af høj kvalitet og lige nu har vi lavet skarpe priser på vores Jun-air kompressorer.
-

Metalbælgkoblinger
Lad Brd. Klee hjælpe med din næste koblingsløsning!
-

Tidsbegrænset projekt? Nyt udstyr? = UDLEJNING
Vi udlejer bl.a. kraner, løfteåg, kædesæt, testudstyr og meget meget mere!
-

Evisa olielamelvakuumpumper til industri og medicinske applikationer
Robust Evisa olielamelvakuumpumper fra Mil's har et højt og stabilt pumpehastighed til slutvakuum samt et lavt støjniveau.
-
TILBUD - MIG/MAG svejsemaskine IMS ARKAD 400T GW3 vandkølet
På undervogn til 50 L flasker – med hjul og integrerede løfteøjer. Integreret vandkøler. Løs tråd boks WF 35 med hjul; til montering på toppen af strømkilden el...